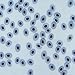
Frog Blood Film Slide, Smear, H&E

Product Information
Specification
Amount : 5.70
Brand : Carolina Biological Supply Company
CurrencyCode : USD
Label : Carolina Biological Supply Company
Manufacturer : Carolina Biological Supply Company
NumberOfItems : 1
PartNumber : 313128
ProductGroup : BISS Basic
ProductTypeName : LAB_SUPPLY
Publisher : Carolina Biological Supply Company
SmallImage_Height : 75
SmallImage_URL : https://m.media-amazon.com/images/I/51kUFe9vVQL._SL75_.jpg
SmallImage_Width : 75
Studio : Carolina Biological Supply Company
Title : Frog Blood Film Slide, Smear, H&E